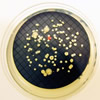
biofilm

Un innovador sistema de alerta automático, capaz de detectar y cuantificar las especies de Legionella en el agua, está siendo desarrollado por la empresa Biótica en el marco del Proyecto Europeo Horizon2020-ULISENS (Ultra Legionella Immunoanalysis System for Early Sensing). El objetivo es reducir el tiempo de respuesta en un 99%, conseguir mayor fiabilidad y menores costes.







 El aire que respiramos en el interior de los edificios condiciona nuestra capacidad de pensar, tomar decisiones y ser productivos. Esta es la conclusión de un estudio realizado en EEUU, que realiza mediciones sobre las funciones cognitivas de orden superior en 24 profesionales, que desarrollan su actividad en oficinas, bajo diferentes condiciones de tres parámetros ambientales: la ventilación con aire exterior, el nivel de CO2 y los compuestos orgánicos volátiles (COVs).
El aire que respiramos en el interior de los edificios condiciona nuestra capacidad de pensar, tomar decisiones y ser productivos. Esta es la conclusión de un estudio realizado en EEUU, que realiza mediciones sobre las funciones cognitivas de orden superior en 24 profesionales, que desarrollan su actividad en oficinas, bajo diferentes condiciones de tres parámetros ambientales: la ventilación con aire exterior, el nivel de CO2 y los compuestos orgánicos volátiles (COVs). Aunque el agua potable utilizada en los hospitales está sometida a tratamientos de desinfección, los biofilms que se forman en las tuberias del edificio son un refugio para las bacterias, incluyendo posibles patógenos, que pueden sobrevivir diferentes estrategias de desinfección. Un estudio realizado en EEUU explora la existencia de un microbioma de los entornos construidos, incluidas comunidades de bacterias viviendo dentro de las tuberías de suministro de agua.
Aunque el agua potable utilizada en los hospitales está sometida a tratamientos de desinfección, los biofilms que se forman en las tuberias del edificio son un refugio para las bacterias, incluyendo posibles patógenos, que pueden sobrevivir diferentes estrategias de desinfección. Un estudio realizado en EEUU explora la existencia de un microbioma de los entornos construidos, incluidas comunidades de bacterias viviendo dentro de las tuberías de suministro de agua. Desde el pasado mes de diciembre, el cáncer de laringe por exposición al amianto está incluido dentro del cuadro de enfermedades profesionales del sistema de la Seguridad Social. Sólidas evidencias científicas han puesto de manifiesto que existe una clara relación entre este tipo de cáncer y el amianto.
Desde el pasado mes de diciembre, el cáncer de laringe por exposición al amianto está incluido dentro del cuadro de enfermedades profesionales del sistema de la Seguridad Social. Sólidas evidencias científicas han puesto de manifiesto que existe una clara relación entre este tipo de cáncer y el amianto.